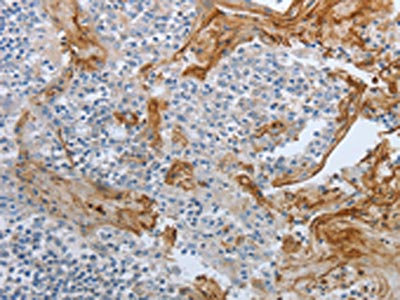

BRAF Antibody
-
中文名稱:BRAF兔多克隆抗體
-
貨號:CSB-PA179620
-
規(guī)格:¥1100
-
圖片:
-
The image on the left is immunohistochemistry of paraffin-embedded Human thyroid cancer tissue using CSB-PA179620(BRAF Antibody) at dilution 1/60, on the right is treated with synthetic peptide. (Original magnification: ×200)
-
The image on the left is immunohistochemistry of paraffin-embedded Human tonsil tissue using CSB-PA179620(BRAF Antibody) at dilution 1/60, on the right is treated with synthetic peptide. (Original magnification: ×200)
-
Gel: 8%SDS-PAGE, Lysate: 50 μg, Lane 1-2: Hela cells, HT29 cells, Primary antibody: CSB-PA179620(BRAF Antibody) at dilution 1/1400, Secondary antibody: Goat anti rabbit IgG at 1/8000 dilution, Exposure time: 5 minutes
-
-
其他:
產品詳情
-
Uniprot No.:
-
基因名:
-
別名:FLJ95109 antibody; 94 kDa B raf protein antibody; B raf 1 antibody; B raf antibody; B Raf proto oncogene serine threonine protein kinase antibody; B Raf proto oncogene; serine/threonine kinase antibody; B RAF1 antibody; B-Raf proto-oncogene serine/threonine-protein kinase (p94) antibody; BRAF 1 antibody; BRAF antibody; BRAF_HUMAN antibody; BRAF1 antibody; cRmil antibody; MGC126806 antibody; MGC138284 antibody; Murine sarcoma viral (v-raf) oncogene homolog B1 antibody; Murine sarcoma viral v raf oncogene homolog B1 antibody; NS7 antibody; Oncogen BRAF antibody; oncogene BRAF1 antibody; p94 antibody; Proto-oncogene B-Raf antibody; Proto-oncogene c-Rmil antibody; RAFB 1 antibody; RAFB1 antibody; RMIL antibody; Serine/threonine-protein kinase B-raf antibody; v raf murine sarcoma viral oncogene homolog B antibody; v raf murine sarcoma viral oncogene homolog B1 antibody; v-Raf murine sarcoma viral oncogene homolog B1 antibody
-
宿主:Rabbit
-
反應種屬:Human,Mouse
-
免疫原:Synthetic peptide of Human BRAF
-
免疫原種屬:Homo sapiens (Human)
-
標記方式:Non-conjugated
-
抗體亞型:IgG
-
純化方式:Antigen affinity purification
-
濃度:It differs from different batches. Please contact us to confirm it.
-
保存緩沖液:-20°C, pH7.4 PBS, 0.05% NaN3, 40% Glycerol
-
產品提供形式:Liquid
-
應用范圍:ELISA,WB,IHC
-
推薦稀釋比:
Application Recommended Dilution ELISA 1:1000-1:5000 WB 1:500-1:2000 IHC 1:50-1:200 -
Protocols:
-
儲存條件:Upon receipt, store at -20°C or -80°C. Avoid repeated freeze.
-
貨期:Basically, we can dispatch the products out in 1-3 working days after receiving your orders. Delivery time maybe differs from different purchasing way or location, please kindly consult your local distributors for specific delivery time.
-
用途:For Research Use Only. Not for use in diagnostic or therapeutic procedures.
相關產品
靶點詳情
-
功能:Protein kinase involved in the transduction of mitogenic signals from the cell membrane to the nucleus (Probable). Phosphorylates MAP2K1, and thereby activates the MAP kinase signal transduction pathway. May play a role in the postsynaptic responses of hippocampal neurons.
-
基因功能參考文獻:
- Development of ultra-short PCR assay to reveal BRAF V600 mutation status in Thai colorectal cancer tissues. PMID: 29879227
- On adjusted analysis specifically of the chemotherapy effect in each subgroup, only patients in the presumed Lynch (HR 0.260, 95% CI, 0.09-0.80, P < 0.01) and other BRAF groups (HR 0.45, 95% CI, 0.23-0.87, P < 0.01) had a significant survival benefit from chemotherapy. PMID: 30399198
- BRAF V600E is associated with distinct histomorphologic features in nevi. These features may contribute to improving the accuracy of classification and diagnosis of melanocytic neoplasms. PMID: 29653212
- Studies have demonstrated that suspicious US features are associated with the BRAFV600E mutation, as well as malignancy in atypia of undetermined significance/follicular lesion of undetermined significance nodules. PMID: 28877096
- It was found that RTK inactivation may help to overcome resistance to B-RAF inhibitors via inhibition of tyrosine kinase phosphorylation and a subsequent blocking of the PI3K-AKT-mTOR and MEK-ERK1/2 downstream signaling pathways. The changes eventually mitigated the cell growth and enhanced the Vemurafenib-dependent cell cycle arrest. PMID: 29989578
- The pan-RAF inhibitor sorafenib is not affected by expression of BRAF deletion variant. PMID: 29605720
- suggests the significance of the BRAFV600E mutation and activation of Wnt signaling pathway in the carcinoma cells PMID: 30223266
- Expression of BRAF V600E, RET/PTC, and concomitant expression of BRAF V600E and RET/PTC were significantly associated with patient age and lymph node metastasis (P<0.05).Of the 50 patients with Papillary Thyroid Carcinoma, 37 patients expressed the BRAF V600E gene mutation, eight patients expressed RET/PTC, and five patients showed concomitant BRAF V600E and RET/PTC. PMID: 30254191
- This study shows the correlation of blood BRAF(V600E) levels in response to treatment in patients with BRAF(V600E)-positive tumors with all stages of disease. PMID: 29378474
- BANCR is downregulated in ccRCC tissues and cell lines, and is associated with ccRCC progression. Thus, BANCR may represent a novel prognostic biomarker and a potential therapeutic target for ccRCC patients PMID: 30200918
- Study reports a S6K/PP1alpha/B-Raf pathway that activates MAPK signaling in PI3K/AKT-driven cancers and is opposed by the promyelocytic leukemia (PML) tumor suppressor. Its importance in regulating prostate cancer cell migration and invasion and in metastatic human prostate cancer is demonstrated. PMID: 29335436
- novel rearrangement of BRAF present in both infantile fibrosarcoma and cellular congenital mesoblastic nephroma PMID: 29915264
- differentially expressed Long Noncoding RNAs correlated with BRAF(V600E) in Papillary Thyroid Cancer. PMID: 28490781
- The data are consistent with independent RNAseq data from serial biopsies of melanoma patients treated with BRAF inhibitors. PMID: 29558679
- trichostatin A does not alter HDAC transcripts nor BRAF itself, but down-regulates critical components of the MAPK/MEK/BRAF oncogenic pathway, initiating a mitotic arrest. PMID: 30194076
- BRAF V600E mutation is associated with increased risk of skin metastases in chemo-resistant metastatic colorectal cancer. PMID: 29380640
- BRAF(V600E) gain-of-function mutation has been reported in over 50% of Erdheim-Chester disease patients. PMID: 29556768
- Presence of BRAFV600E mutations in melanoma is detecting by immunochemistry using clone VE1. PMID: 29221650
- results confirm that BRAF V600E-positive hairy cell leukemia is a relatively rare disorder in the Japanese leukemia patient population. PMID: 30043333
- BRAF and EGFR inhibitors are able to synergize to increase cytotoxic effects and decrease stem cell capacities in BRAF(V600E)-mutant colorectal cancer cells PMID: 29534162
- A diligent morphological examination to look for the presence of hairy cells along with flow cytometric immunophenotyping showing consistent bright expression of CD200, in addition to well-described characteristic immunophenotype, helps in correctly diagnosing the case. This can be further confirmed by the consistent presence of V600E point mutation in BRAF gene. PMID: 30197362
- BRAF mutations are associated with colorectal liver metastases. PMID: 29937183
- Multivariate analyses revealed that the PIK3CA mutation and clinical T stage were independent favorable prognostic factors (hazard ratio 0.34, 95% confidence interval: 0.12-0.96, p = 0.042). PIK3CA mutations were significantly associated with APC alterations (p = 0.0007) and BRAF mutations (p = 0.0090). PMID: 30115035
- The present findings suggested that miR9 may suppress the viability ofpapillary thyroid carcinoma (PTC) cells and inhibit tumor growth through directly targeting the expression of BRAF in PTC. PMID: 29767243
- MET inactivation in the context of the BRAF-activating mutation is driven through a negative feedback loop involving inactivation of PP2A phosphatase, which in turn leads to phosphorylation on MET inhibitory Ser985. PMID: 30224486
- Data show that glycogen synthase kinase 3 (GSK3) and proto-oncogene proteins B-raf (BRAF)/MAPK signaling converges to control microphthalmia-associated transcription factor MITF (MITF) nuclear export. PMID: 30150413
- these results indicated that STAT3-mediated downexpression of miR-579-3p caused resistance to vemurafenib. Our findings suggest novel approaches to overcome resistance to vemurafenib by combining vemurafenib with STAT3 sliencing or miR-579-3p overexpression. PMID: 30010109
- Despite the presence of histological findings indicating long-standing gastroesophageal reflux in 25%, as well as symptomatic gastroesophageal reflux in more than 40%, there was no detectable tissue expression of KRAS or BRAF mutations in adult patients treated for esophageal atresia in childhood. PMID: 28873491
- A report of BRAF mutations in acute myeloid leukemias (AML) found mutations only in de novo AML with monocytic differentiation. PMID: 27545333
- The occurrence of BRAF V600E mutations in ganglioglioma is common, and their detection may be valuable for the diagnosis and treatment in ganglioglioma. PMID: 30220118
- Following adjustment for sex, logistic regression analysis showed that BRAFV600E mutation, transforming growth factor beta (TGF-beta) expression, age, and tumor size are risk factors that can affect tumor clinical stage (p < 0.05). Based on the results of this analysis, we generated a matrix that incorporated 4 variables: patient age, tumor size, BRAFV600E mutation, and TGF-beta expression. PMID: 28892804
- Studied frequency of BRAF 1799T>A mutation in Mexican Papillary Thyroid Cancer patients. PMID: 29808165
- The frequency of BRAF mutations was significantly higher in Serrated Lesions subgroups with highly methylated epigenotype tumors and microsatellite instability. PMID: 29974407
- The rate of EGFR mutation was significantly higher in female and non-smoker patients. In TTF-1 positive cases EGFR mutation was more frequent. Age of the patients over 62-year old was correlated with KRAS mutations. The concordance between ALK IHC and FISH was 58.3%. The MET protein in the cases with MET amplification was 100% positive. PMID: 28756651
- Lower CA125 serum levels, negative vascular invasion, and wild-type BRAF status were significantly associated with improved 2-year DFS rates among patient with stage III disease who received adjuvant chemotherapy. PMID: 29562502
- genetic association/nutrigenomic studies in population in Seoul, Republic of Korea: Data suggest that (1) relatively low iodine intake and (2) more than excessive iodine intake are significant risk factors for occurrence of BRAF mutations in thyroid gland and may be risk factors for development of PTC (papillary thyroid cancer) in iodine-replete area. PMID: 28258306
- The BRAF gene has been reported to be mutated in some human cancers. The BRAF mutations have been implicated in ameloblastoma. PMID: 28650588
- The BRAFV600E mutation status may not impact the clinical response to radioiodine therapy for papillary thyroid carcinoma patients PMID: 29762246
- Children with Langerhans cell histiocytosis (LCH) tend to have a high overall survival rate and a high incidence rate of BRAF-V600E mutation. PMID: 29658453
- BRAF mutations more frequently affected individuals younger than 61 with phototype II. In contrast, NRAS mutations were more frequent in phototype III cases. Mutations of both genes were more frequent in cases with satellitosis in the first melanoma, and in cases with ulceration in the subsequent lesions. PMID: 29180316
- Identification of KRAS/NRAS/BRAF mutation status is crucial to predict the therapeutic effect and determine individual therapeutic strategies for patients with colorectal cancer. PMID: 29335867
- we did not observe GNAS or BRAF mutations in urachal adenocarcinomas PMID: 28285720
- Study finds infrequent BRAF alterations but enriched FGFR alterations in adults as compared with that reported in pediatric pilocytic astrocytomas. In addition, coexistent BRAF and FGFR alterations and a significant association of FGFR alterations with age and tumor location were noted. PMID: 27608415
- a low frequency of BRAF or KRAS mutation in Chinese patients with low-grade serous carcinoma of the ovary PMID: 29273082
- genetic association studies in population in China: Data suggest that, in patients with unilateral papillary thyroid carcinoma, a mutation in BRAF (V600E) plus multi-focality are both independently and synergically associated with CLNM (central lymph node metastasis) in the population studied. PMID: 29070763
- RHEB Y35N expressing cells undergo cancer transformation due to decreased interaction between RHEB and BRAF resulting in overactive RAF/MEK/ERK signaling. Taken together with the previously established function of RHEB to activate mTORC1 signaling, it appears that RHEB performs a dual function; one is to suppress the RAF/MEK/ERK signaling and the other is to activate mTORC1 signaling. PMID: 29320991
- The MLH1-93 AA genotype is significantly associated with promoter hypermethylation and MLH1 loss in the context of Sessile serrated adenoma of dysplasia. BRAF mutant microsatellite stable colorectal cancers with the AA genotype most likely arise in traditional serrated adenomas since the A allele does not predispose to methylation in this context. PMID: 29304767
- Knowing the mutation status of KRAS, BRAF or PIK3CA in stage II colorectal cancer can significantly improve the accuracy of prognoses. PMID: 28685592
- Mutated Liquid-based FNAs BRAF, N/HRAS and TERT mutations were significantly associated with malignancy regardless of the cytological classification PMID: 29094776
- our study suggests that an activating BRAF I463T mutation was associated with eosinophilic cystitis. Importantly, analysis of ctDNA obtained through "liquid biopsies" can identify potentially important genomic alterations in patients for whom biopsy may be difficult in terms of risk or cost. PMID: 28829677
顯示更多
收起更多
-
相關疾病:Colorectal cancer (CRC); Lung cancer (LNCR); Familial non-Hodgkin lymphoma (NHL); Cardiofaciocutaneous syndrome 1 (CFC1); Noonan syndrome 7 (NS7); LEOPARD syndrome 3 (LPRD3)
-
亞細胞定位:Nucleus. Cytoplasm. Cell membrane.
-
蛋白家族:Protein kinase superfamily, TKL Ser/Thr protein kinase family, RAF subfamily
-
組織特異性:Brain and testis.
-
數(shù)據(jù)庫鏈接:
Most popular with customers
-
-
YWHAB Recombinant Monoclonal Antibody
Applications: ELISA, WB, IHC, IF, FC
Species Reactivity: Human, Mouse, Rat
-
-
-
-
-
-